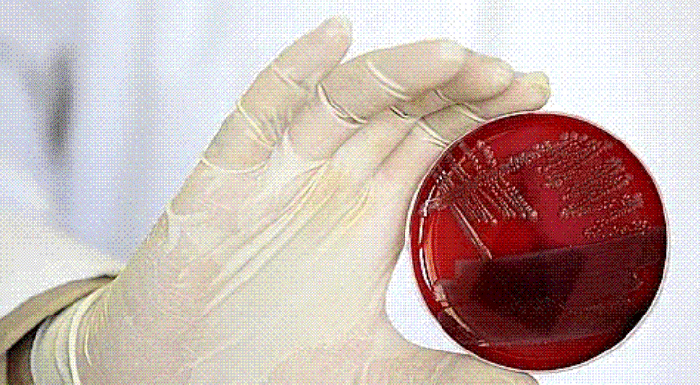

Бактерия-«убийца» и потерянная продовольственная безопасность России
12 cтран сообщили о фактах заражения «бактерией-убийцей», вызвавшей кишечную эпидемию в Европе. По данным ВОЗ, её жертвами стали 18 человек (17 в Германии, 1 – в Швеции), а всего заболело более 2 тысяч. Инкубационный период – 3-4 дня. Случаи гемолитического и уремического синдрома отмечены, кроме Германии и Швеции, в Австрии, Великобритании, Чехии, Дании, Франции, Голландии, Норвегии, Испании, США.
Вчера Россия запретила ввоз всех овощей из стран Евросоюза, что вызвало у них недовольную реакцию. Представитель ЕС в Москве Ф.Валенсуэла заявил, что запрет идет вразрез с принципами ВТО, куда Россия собирается вступить.
Ещё бы. Экспортёры от эмбарго теряют в неделю до 200 миллионов долларов.
Итак, дожили. «Партнёры» усиливают диктат. Россия, подсаженная, помимо всяких других игл и на иглу продовольствия, оправдывается. Ещё в самом первом заявлении Г.Онищенко о возможности введения запрета, он выражал понимание того, что для «партнёров» это сопряжено с финансовыми потерями. Меня это покоробило.
Уместно ли говорить о чьих-то потерях перед лицом опасности для здоровья, а то и жизни, своих, российских граждан?
Получается, мы-то с Европой весьма дипломатичны, и прежде своих входим сначала в её интересы. А она не миндальничает, а нагло нажимает на больную кремлёвскую мозоль дикого стремления в ВТО. Да и внутри страны сразу находится немало подголосков Европы, которые начинают нас стращать всплеском инфляции, подъемом цен отечественных производителей, возможным дефицитом овощной продукции.
Вспомнила бабка, что девкой была. А как же без повышения цен? Чай у нас рынок, а не какая-то плановая фигня.
Не надо было терять продовольственную безопасность. Ишь ты, солёные огурцы «Дядя Вася» за три моря закупаем. В России-то они не растут. Прямо как спаржа какая-нибудь. А в Воронежской области огурцы-желтяки в домашних хозяйствах (которые сами жители не в состоянии оприходовать для семейных нужд, а сдать их на заготовки местным кооператорам, как раньше, невозможно) прямо с грядок отправляют в компост.
Собственные тепличные предприятия, оказывается, развивать невыгодно из-за: а) сильно подорожавших энергоносителей, б) отсутствия отечественной семенной базы, в) дороговизны импортного оборудования.
Вот как аукнулись либеральные стоны 90-х годов о российском сельском хозяйстве как «чёрной дыре», в которую бесполезно вбухивать бюджетные средства поддержки!
Теперь в нашем АПК, как признавалось на V Национальном конгрессе «Приоритеты развития экономики и модернизации промышленности России», износ основных фондов зашкалил за 70 процентов, производительность труда упала вдвое против советского уровня и в 7-10 раз по сравнению со странами «большой восьмёрки». Аграрный сектор попал в беспрецедентную зависимость от зарубежья в научно-технологическом отношении. Доля закупок иностранных сортов в общем посеве овощных культур – 70 процентов, сахарной свёклы – 48, кукурузы – 40, племенного скота - половина, тракторов – 70 процентов, доильного оборудования – 95 процентов. И так по многим другим позициям.
Вопрос только один: кто за это ответит?
На снимке: ни происхождение, ни способ проникновения в организм человека бактерии-"убийцы" пока неизвестны.

Комментарии